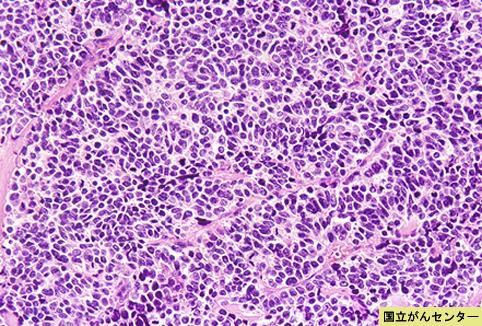

Detailed data.
| Criteria of Hist.Classification | Malignant epithelial tumor/Undifferentiated carcinoma |
| Location | Large intestine(Colon)/Ascending colon |
| Technique, Method | Histology |
| Macroscopic Types | Type 5 Unclassfied type/ |
| Size | 40 - |
| Depth of Tumor Invasion | serosa (adventitia) |
| Multiple neoplasm in same organ | Non |
| Multiple neoplasm in another | Non |